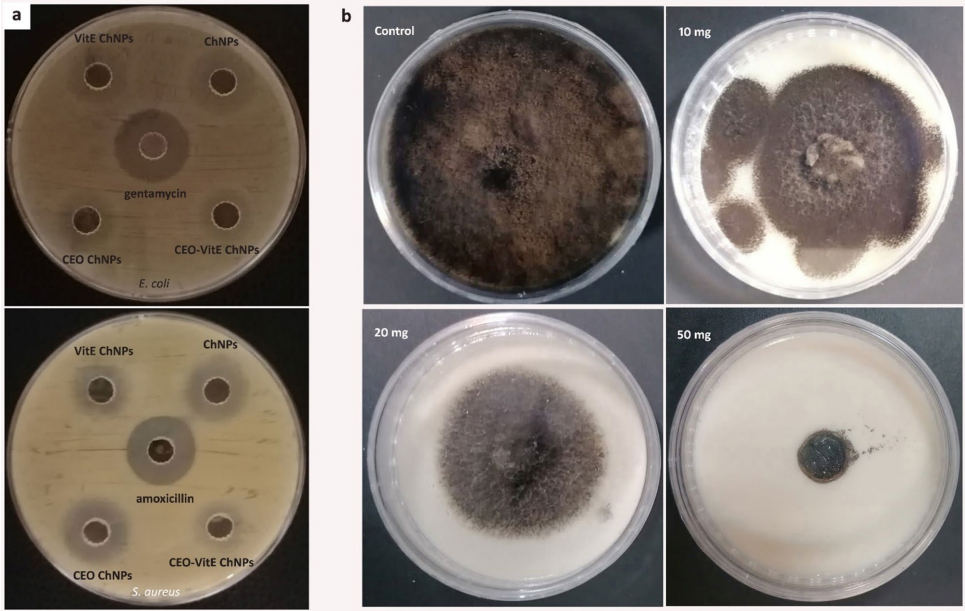

-
生物通官微
陪你抓住生命科技
跳动的脉搏
维生素E与丁香油共载壳聚糖纳米粒的合成及其抗氧化抗菌机制研究
【字体: 大 中 小 】 时间:2025年09月02日 来源:Scientific Reports 3.9
编辑推荐:
本研究针对食品工业中维生素E(Vit E)和丁香油(CEO)因疏水性和不稳定性导致应用受限的问题,通过乳液/离子凝胶法成功制备了共载壳聚糖纳米粒(ChNPs)。该纳米载体显著提升了活性成分的稳定性与生物利用度,ABTS/DPPH实验显示其抗氧化活性达75.66-77.7%,对金黄色葡萄球菌(S. aureus)和大肠杆菌(E. coli)的抑菌圈达14-17 mm,并完全抑制黑曲霉(A. niger)生长。分子对接证实壳聚糖(Ch)、丁香酚和α-生育酚与微生物靶蛋白强结合,为开发天然食品防腐剂提供了新策略。
在食品工业中,植物精油(EOs)和维生素等活性成分因其卓越的抗氧化和抗菌特性备受关注,但它们的挥发性、光热敏感性和水溶性差等"先天缺陷"严重制约了实际应用。以丁香油(CEO)为例,虽然其富含的丁香酚(eugenol)具有广谱抗菌作用,但在加工和储存过程中极易分解;同样,维生素E(Vit E)作为脂溶性抗氧化剂,也难以在水基食品体系中发挥作用。如何让这些"娇气"的活性成分保持稳定并高效释放,成为食品科学领域的重大挑战。
针对这一难题,伊朗伊斯法罕大学的Davoud Mahmoudi团队在《Scientific Reports》发表研究,创新性地采用乳液/离子凝胶法,将CEO与Vit E共载于壳聚糖纳米粒(ChNPs)中。这种绿色制备工艺无需有毒表面活性剂,通过壳聚糖(Ch)与三聚磷酸钠(TPP)的静电作用自组装成纳米载体,既保留了生物活性又实现了协同增效。研究人员通过动态光散射(DLS)、透射电镜(TEM)等技术证实获得了粒径<50 nm的单分散纳米粒,其表面丰富的羟基和氨基赋予优异的胶体稳定性。
关键技术方法
研究采用乳液/离子凝胶两步法:先将CEO与Vit E超声乳化于壳聚糖醋酸溶液,再通过TPP交联固化。通过正交实验优化Ch/TPP质量比(0.5:1)和油相浓度(7.4 mg mL-1)。采用ABTS/DPPH法评估抗氧化活性,通过琼脂扩散法和微量肉汤稀释法测定对S. aureus和E. coli的抗菌效果,MTT法检测人成纤维细胞毒性。分子对接模拟采用HDOCK服务器分析Ch、丁香酚与α-生育酚对微生物靶蛋白的结合模式。
主要研究结果
Synthesis of ChNPs and their loading with CEO and Vit E
优化后的CEO-Vit E ChNPs在4℃下可稳定储存3个月以上,其流体力学直径由198.1 nm增至306.6 nm,透射电镜显示实际粒径<50 nm。

Antioxidant activity measurement
共载纳米粒的ABTS自由基清除率(75.66%)显著高于游离CEO(55.97%),48小时内Vit E的缓释使其抗氧化活性从36.2%提升至77.7%。
In vitro cell studies
CEO-Vit E ChNPs对S. aureus的抑菌圈达16.1 mm,最小抑菌浓度(MIC)为987.5 μg mL-1,50 mg mL-1浓度可完全抑制A. niger生长。MTT实验显示载药纳米粒的细胞存活率(72.84%)显著高于空白ChNPs(35.61%)。
Molecular docking
壳聚糖六聚体与S. aureus DNA旋转酶(PDB 2XCT)的结合能达-343.58,形成22个氢键;α-生育酚与烟曲霉角鲨烯环氧化酶(PDB 4UYM)的结合能为-173.11,显著优于丁香酚(-104.25)。
结论与意义
该研究开创性地构建了CEO-Vit E共载壳聚糖纳米递送系统,其多重优势体现在:① 离子凝胶法制备工艺绿色简便,避免使用有毒乳化剂;② 纳米载体使疏水性活性成分的ABTS清除率提升20%,抗菌效果优于部分抗生素;③ 分子层面揭示了Ch通过破坏微生物细胞壁合成(MurA)、DNA复制(旋转酶)和膜稳定性(角鲨烯环氧化酶)的多靶点作用机制。这种"天然抗菌剂+营养强化剂"的纳米共载策略,为开发功能性食品防腐剂提供了新范式,有望替代传统化学防腐剂应用于烘焙食品、生鲜包装等领域。未来研究可进一步探索该体系在肠道健康、伤口敷料等跨学科领域的应用潜力。
生物通微信公众号
知名企业招聘